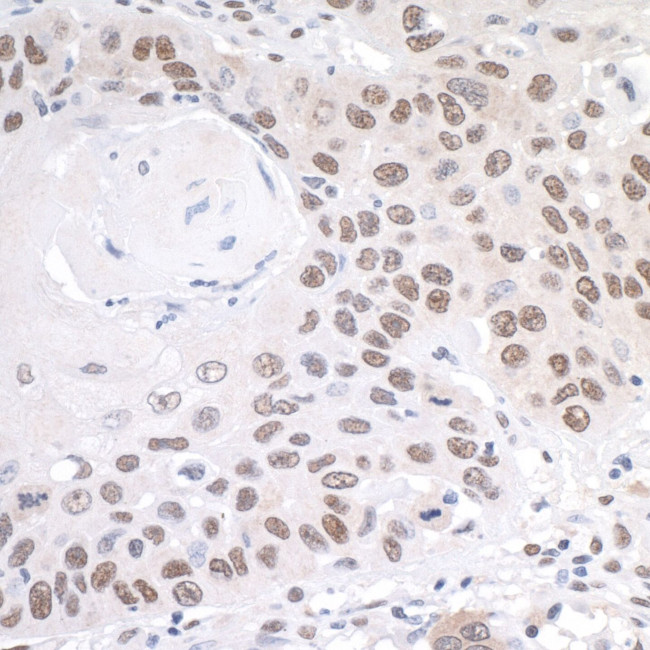
PRMT1 Antibody in Immunohistochemistry (IHC)

Search
Bethyl Laboratories
PRMT1 Polyclonal Antibody
{{$productOrderCtrl.translations['antibody.pdp.commerceCard.promotion.promotions']}}
{{$productOrderCtrl.translations['antibody.pdp.commerceCard.promotion.viewpromo']}}
{{$productOrderCtrl.translations['antibody.pdp.commerceCard.promotion.promocode']}}: {{promo.promoCode}} {{promo.promoTitle}} {{promo.promoDescription}}. {{$productOrderCtrl.translations['antibody.pdp.commerceCard.promotion.learnmore']}}
产品信息
A300-723A
宿主/亚型
分类
类型
抗原
偶联物
形式
浓度
规格
保存条件
运输条件
产品详细信息
The recommended shelf life for this product is 1 year from date of receipt.
Application Note: For IHC, epitope retrieval with citrate buffer pH 6.0 is recommended for FFPE tissue sections.
Based on 100% sequence identity, this antibody is predicted to react with Rat, X. laevis and X. tropicalis
靶标信息
PRMT1 is a member of the protein arginine N-methyltransferase (PRMT) family. Arginine methylation is an irreversible post translational modification which has been implicated in RNA processing and trafficking, receptor-mediated signaling, and transcription. At least three types of PRMT enzymes have been identified in mammalian cells. These enzymes have been shown to have essential regulatory functions by methylation of key proteins in several fundamental areas. These proteins include nuclear proteins, IL enhancer binding factor, nuclear factors, cell cycle proteins, signal transduction proteins, apoptosis proteins, and viral proteins. The mammalian PRMT family currently consists of 7 members that share two large domains of homology. Increased expression of PRMT1 may play a role in various types of cancer.
仅用于科研。不用于诊断过程。未经明确授权不得转售。